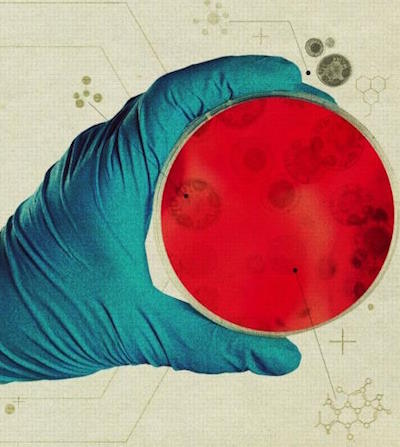
���������� �����

Достижения, которые вызывают смех, а затем – раздумья
Что такое зеркальная жизнь? Учёные бьют тревогу
зеркальные клетки могут стать реальностью в ближайшие 10–30 лет

отчет по зеркальным бактериям
Кейт Адамала (Katarzyna Adamala), Университет Миннесоты, США, Джонатан Джонс (Jones, Jonathan), Университет Восточной Англии, и ещё 22 специалиста, "Технический отчет по зеркальным бактериям: осуществимость и риски", Стэнфордский университет, 3.12.2024.
Многие ключевые молекулы, общие для всех живых организмов, хиральны: их зеркальные отражения не могут быть наложены друг на друга. В природе почти все аминокислоты и сахара преимущественно присутствуют только в одной из двух возможных зеркальных форм. Синтетические зеркальные полипептиды и нуклеиновые кислоты складываются в идеальные зеркальные отражения своих природных аналогов и взаимодействуют идентично с зеркальными отражениями своих природных субстратов. Тот же принцип применим и к другим биологическим структурам. Масштабируя эту логику, зеркальная ячейка, в которой все молекулы заменены своими зеркальными отражениями, будет функционировать идентично ячейке с естественной хиральностью, но с точным зеркальным отражением.

Кейт Адамала (Katarzyna Adamala)
Ученые давно рассматривают возможность создания зеркальных ячеек, включая зеркальные бактерии. В изоляции они будут вести себя идентично бактериям с естественной хиральностью — зеркальные бактерии будут расти в тех же физических условиях и с той же скоростью на ахиральных питательных веществах. Но, поскольку естественная жизнь хиральна, взаимодействия между природными организмами и зеркальными бактериями будут глубоко изменены. В этом отчете описывается техническая осуществимость создания зеркальных бактерий и потенциально серьезные риски, которые зеркальная жизнь может представлять для людей, других животных, растений и окружающей среды.

Джонатан Джонс (Jones, Jonathan)
Надежные зеркальные бактерии могут быть разработаны в ближайшие годы и будут уязвимы к случайному или преднамеренному неправильному использованию.
Создать живую клетку из неживых предшественников пока невозможно. Несмотря на серьезные технические трудности, представляется вероятным, что этого можно будет достичь всего за десятилетие при достаточных ресурсах. Как только будут разработаны методы создания клеток с естественной хиральностью, аналогичный подход может быть использован для создания зеркальных клеток из зеркальных компонентов.
Небольшая группа исследователей и спонсоров начала целенаправленную работу над созданием зеркальной жизни, уделяя особое внимание подходу «снизу вверх», в котором зеркальный геном, а также аппараты транскрипции и трансляции используются для создания других зеркальных клеточных компонентов. Современные методы синтеза белка в принципе достаточны для синтеза большинства зеркальных белков, необходимых для создания зеркальной клетки, хотя в настоящее время это сопряжено с непомерно высокими затратами. Зеркально-отражающие ферменты недавно были использованы для конструирования зеркальных РНК и ДНК длиной в килобаз, и исследования продвигаются в направлении создания зеркальной рибосомы.
Возможны и другие пути создания зеркальных бактерий. Например, подход «сверху вниз», при котором бактерия с естественной хиральностью поэтапно превращается в зеркальную бактерию, может стать технически осуществимым по мере развития трансляционной инженерии.
Первая зеркальная бактерия, вероятно, будет хрупким микробом с метаболическими дефектами, которые ограничат ее рост и выживаемость вне лаборатории. Однако после создания зеркальные бактерии можно будет легко модифицировать, сделав их более устойчивыми, используя стандартные методы для создания зеркальных версий существующих бактериальных генов. Это может дать им новые возможности или даже превратить их в Зеркальные версии существующих устойчивых бактерий. Добавление зеркальных версий известных метаболических путей позволит зеркальным бактериям использовать глюкозу с естественной хиральностью и другие распространённые сахара. Меры биосдерживания могут гарантировать, что зеркальные бактерии не смогут выжить вне лаборатории.
Однако эти меры будут уязвимы для человеческих ошибок или преднамеренного неправильного использования.
Достижение надёжного биосдерживания, которое не смог бы преодолеть человек средней квалификации, имеющий доступ к зеркальной ДНК, не представляется возможным.
Зеркальные бактерии могут обходить многие аспекты человеческого иммунитета и потенциально вызывать опасную для жизни инфекцию.
Большинство иммунологических механизмов основаны на точных стереоспецифических взаимодействиях между макромолекулами хозяина и патогена. Зеркальные макромолекулы зеркальных бактерий, вероятно, не смогут должным образом связываться с рецепторами, ферментами или другими эффекторами хозяина, поскольку они будут иметь «неправильную» хиральность. Это может дать зеркальным бактериям степень внутренней иммунной уклончивости, значительно превышающую возможности любого известного природного патогена.
Иммунная система может быть ослаблена тремя основными способами. Во-первых, врожденный иммунный ответ основан на первоначальном обнаружении консервативных микробных биомолекул, таких как бактериальные липополисахариды и пептидогликаны, рецепторами распознавания образов хозяина. Поскольку эти молекулы почти исключительно хиральны, иммунное распознавание зеркальных бактерий может быть существенно нарушено. Во-вторых, многие врожденные иммунные механизмы контроля патогенов могут быть прямо нарушены; например, фагоцитоз, антимикробные ферменты и несколько путей системы комплемента основаны на стереоспецифических белковых взаимодействиях.
Наконец, зеркальные белки будут противостоять деградации и другим стереоспецифическим механизмам, необходимым для обработки и презентации антигена врожденными иммунными клетками, что может нарушить активацию адаптивных Т- и В-иммунных клеток и выработку антител. Воздействие на человека зеркальных организмов, обладающих внутренней иммунологической устойчивостью, может привести к инфекции и возможно, к смерти. Хотя у зеркальных бактерий отсутствуют функциональные факторы вирулентности, облегчающие инвазию, транзиторные бактериемии, вызванные бактериями окружающей среды, распространены, что позволяет предположить, что воздействие зеркальных бактерий через вдыхание, проглатывание, микротравмы или раны может привести к пассивной транслокации через эпителиальные барьеры.
Попав внутрь, зеркальные версии обычных бактерий, таких как Escherichia coli, смогут расти на ахиральных питательных веществах, таких как глицерин, и, при соответствующей модификации, на глюкозе и других хиральных питательных веществах. Ослабленный иммунитет, вероятно, позволит им широко размножаться в кровотоке. Точная клиническая картина зеркальной бактериальной инфекции неясна, но при отсутствии эффективного иммунного ответа летальный исход представляется весьма вероятным.
Варианты лечения будут ограничены. Большинство антибиотиков стереоспецифически взаимодействуют со своими микробными мишенями, поэтому существующие запасы будут ограничены несколькими ахиральными или рацемическими антибиотиками. Поскольку это новое инфекционное заболевание, для него не будет предсуществующей вакцины. Разработка новых антизеркальных соединений и конъюгированных вакцин должна быть возможной; тем не менее, как и в случае с новой пандемией, практические проблемы с быстрой и масштабной разработкой таких мер будут значительными.
Зеркальные бактерии потенциально могут инфицировать многих других животных и растения и колонизировать некоторые внешние среды, вызывая необратимые экологические нарушения.
Другие многоклеточные организмы могут быть столь же уязвимы к зеркальной бактериальной инфекции. Позвоночные имеют в целом схожую иммунную систему и, вероятно, страдают от тех же дефектов, что и человек. Иммунная система беспозвоночных более изменчива и менее изучена, но может быть также неэффективна. Например, модельное насекомое Drosophila melanogaster полагается на распознавание пептидогликана для запуска антибактериальных иммунных механизмов, и поэтому вряд ли распознает зеркальные бактерии. Модельная нематода Caenorhabditis elegans, по-видимому, полагается не на распознавание молекул, ассоциированных с патогеном, а на избегание патогена и распознавание повреждений хозяина; последнее может позволить или не позволить нематодам пережить зеркальную бактериальную инфекцию.
Поедание тканей инфицированного организма хищником или падальщиком может привести к инфекции, вызывая распространение зеркальных бактерий по пищевой сети. Иммунная система растений также опирается на обнаружение консервативных биомолекул патогенов. Почти все известные иммунные рецепторы растений распознают хиральные лиганды и, следовательно, вряд ли будут распознавать зеркальные бактерии. Хотя зеркальные бактерии изначально не обладают специфическими адаптациями для проникновения и колонизации растений, как корни растений, так и устьица листьев могут обеспечивать пассивную транслокацию зеркальных бактерий из окружающей среды. Могут ли зеркальные бактерии распространяться через сосудистую систему, неясно, и это может варьироваться для разных видов растений, но если системное заражение все же произойдет, оно может оказаться фатальным. Ключевые сельскохозяйственные культуры, вероятно, можно было бы модифицировать так, чтобы они стали устойчивыми, но защита диких растений и связанных с ними экосистем будет невозможна.
Помимо того, что зеркальные бактерии могут функционировать как опасный «случайный патоген» для широкого спектра видов с естественной хиральностью, зеркальные бактерии могут сохраняться внутри и потенциально колонизировать внешнюю среду. В отличие от своих аналогов с естественной хиральностью, зеркальные бактерии будут полностью устойчивы ко всем бактериофагам, частично уклоняются от хищников и в значительной степени неперевариваются ими, а также в значительной степени устойчивы к антимикробным соединениям, выделяемым конкурирующими видами микроорганизмов.
Эти потенциально решающие конкурентные преимущества могут позволить достаточно устойчивым зеркальным бактериям успешно вторгаться во многие экологические ниши, несмотря на отсутствие специфических адаптаций.
Поскольку хищники не смогут переварить большинство зеркальных макромолекул, растущая популяция зеркальных бактерий не будет контролироваться соразмерным ростом хищничества, что могло бы позволить популяциям достичь высокой численности.
После высвобождения инвазивные зеркальные бактерии могут быстро распространяться инфицированными животными и людьми, а также путем транспортировки зараженных товаров и продуктов. Хотя выпущенная зеркальная бактерия, вероятно, будет иметь мало предсуществующих генетических вариаций и не сможет переносить гены с бактериями с естественной хиральностью, за этим последуют эволюционная диверсификация и адаптация для расширения круга среды и хозяев зеркальных бактерий.
Зеркальные бактерии могут напрямую привести к вымиранию уязвимых видов растений и животных, а потеря уязвимых «ключевых видов» может косвенно спровоцировать серьёзные экологические нарушения.
Очень большие популяции зеркальных бактерий, особенно автотрофных зеркальных бактерий, могут нарушить круговорот питательных веществ во многих экосистемах и повлиять на глобальный углеродный цикл. Экологические контрмеры, такие как синтез и высвобождение зеркальных фагов, нацеленных на инвазивные зеркальные бактерии, могут снизить их максимальную численность популяции, но имеют мало реальных перспектив предотвращения этих крупных и необратимых последствий.
Есть и другие мнения. Зеркальная жизнь всё ещё скорее научная фантастика, чем научный факт. Исследования сейчас находятся на очень ранней стадии и далеки от угрозы. Учёные пытались создать синтетическую жизнь, используя незеркальные молекулы, уже более 10 лет, но до появления самоподдерживающихся клеток, способных делиться, размножаться и эволюционировать, они всё ещё очень далеки, это в тысячи раз сложнее. Масштаб сложности похож на то, как люди готовятся к посадке на Марс, но начинают говорить о полёте к другим звёздам и галактикам.
Тем не менее, зеркальные клетки могут стать реальностью в ближайшие 10–30 лет, в отчёте подробно описаны потенциально разрушительные последствия, если зеркальные бактерии будут выпущены в окружающую среду и распространятся, избегая естественного биологического контроля, выступая в роли опасных патогенов.
02.12.2025
(c)2010-2026 Шнобелевская премия
ig-nobel@mail.ru
ig-nobel@mail.ru